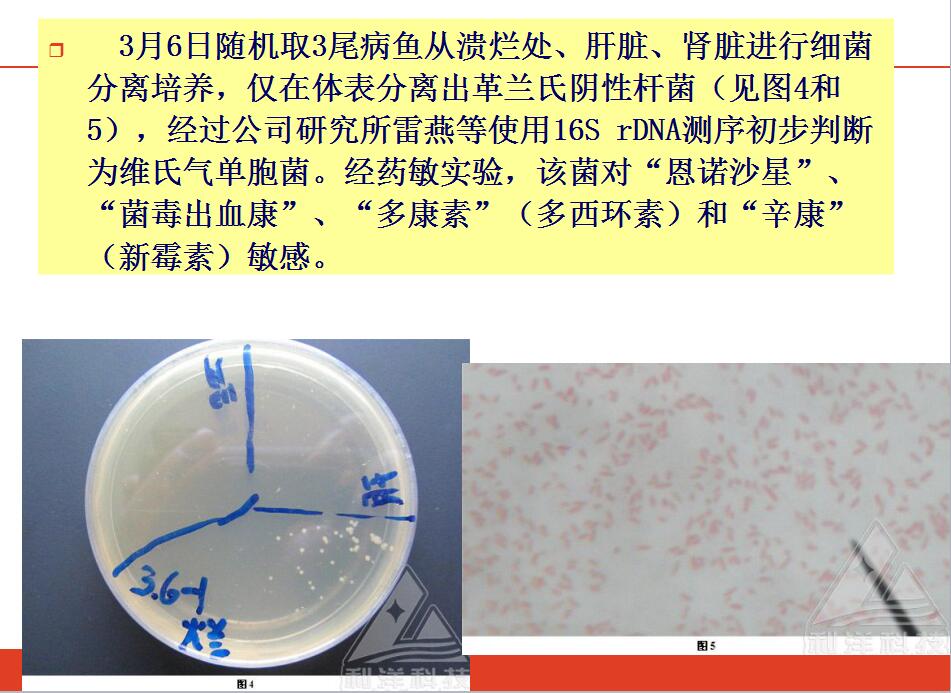

子项目二 以溃烂为主的疾病诊治
-
1 课前预习
-
2 知识扩展1
-
3 知识扩展2
-
4 案例
上一节
下一节
体表以溃烂为主的疾病诊治
注:拉网易造成鱼体损伤,继发细菌感染,即可引起体表溃烂
病例图片: